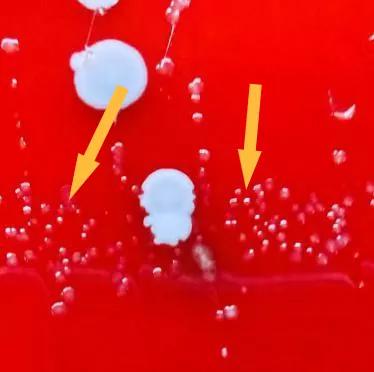
窥一斑而识全貌,窥一斑而知全貌出自哪里

来源: 检验医学
姐,窗口来个长腿帅哥!
咋?
没啥,你猜验啥?
淋球菌培养
可惜…
…花痴!

(图片来源:网易新闻)
2013-2016全国(淋病)资料显示,15-29岁青少年中,除个别年份淋病发病率存在轻微下滑后,再次显现回升苗头。
给淋病把把脉
本文以LIS系统检索2019年某三甲综合性医院淋球菌培养272份,作为样本单元,剔除信息不全1例,全年共检出淋病奈瑟菌42株,阳性率为15.50%(42/271);分析42株淋病奈瑟氏菌患者年龄、性别分布、就医类型等临床资料,找寻实验诊断背后疾病的更多讯息。
1.材料&实验路径

挑取原培养疑似菌落




CA35℃5% CO2 24/48H分纯后菌落




(上机鉴定符合率95-99%)
小 结
少量NG(2/42)菌株血平板上生长良好,如遇血平板中奈瑟菌属为优势株时,应考虑NG感染可能,以防漏检(见上图)。
革兰染色+触酶+氧化酶手工试验是鉴定奈瑟菌属的必选实验,手工试验因其影响因素较多(革兰染色中的脱色时间、氧化酶试剂配制时间等),试验稳定性欠佳,解决的办法除应严格按照本室SOP操作外,还应建立完善室内质量控制,以保证后续鉴定结论准确。
怀疑NG时,分纯菌落时应加种(密涂)巧克力平板,以保证上机前获取充足菌落。
02、42株GNH患者临床资料
年龄分布(岁)

15-29岁年龄组占比为71.42%,中位年龄:23.5岁
性别比例
男/女=41:1
就诊类型
门诊/住院=41:1
样本类型
分泌物/尿液=40:2
送检科室

小结
青少年组阳性株数检出率最高,考虑与该年龄段*行为性**活跃,不洁*行为性**发生率较高有关;
男女比例差异大,考虑与男性GNH患者症状明显,就医意愿强有关,女性GNH患者检出低,与女性发病相对隐匿(50%的女性宫颈淋病无临床症状),存在有偿*服务性**人群等因素有关;
理论上女性患者中存在较大漏检人数,门诊/住院比例差异大,治疗上多以三代头孢(如头孢曲松)+氟喹诺酮类(如左氧氟沙星)经验性用药为主。
超级淋病

超级淋病是淋病奈瑟菌的最新变种,2013年5月在日本发现。这种新型细菌可抵御头孢菌素。由研究人员从一名日本*服务性**者的喉部分离出来,被命名为"H041"。
新变种菌株能够抵御所有抗生素,轻易地摆脱药物作用,对公共卫生构成严重威胁。H041的侵袭力相当强,能在短时间内使更多的人感染,被感染者可在短时间内出现脓毒休克症状,甚至死亡。其传染性或超艾滋病。
【参考文献】
[1]https://www.cdc.gov/drugresistance/biggest-threats.html?CDC_AA_refVal=https%3A%2F%2Fwww.cdc.gov%2Fdrugresistance%2Fbiggest_threats.html#nei
#医师报超能团#
#超能健康团#